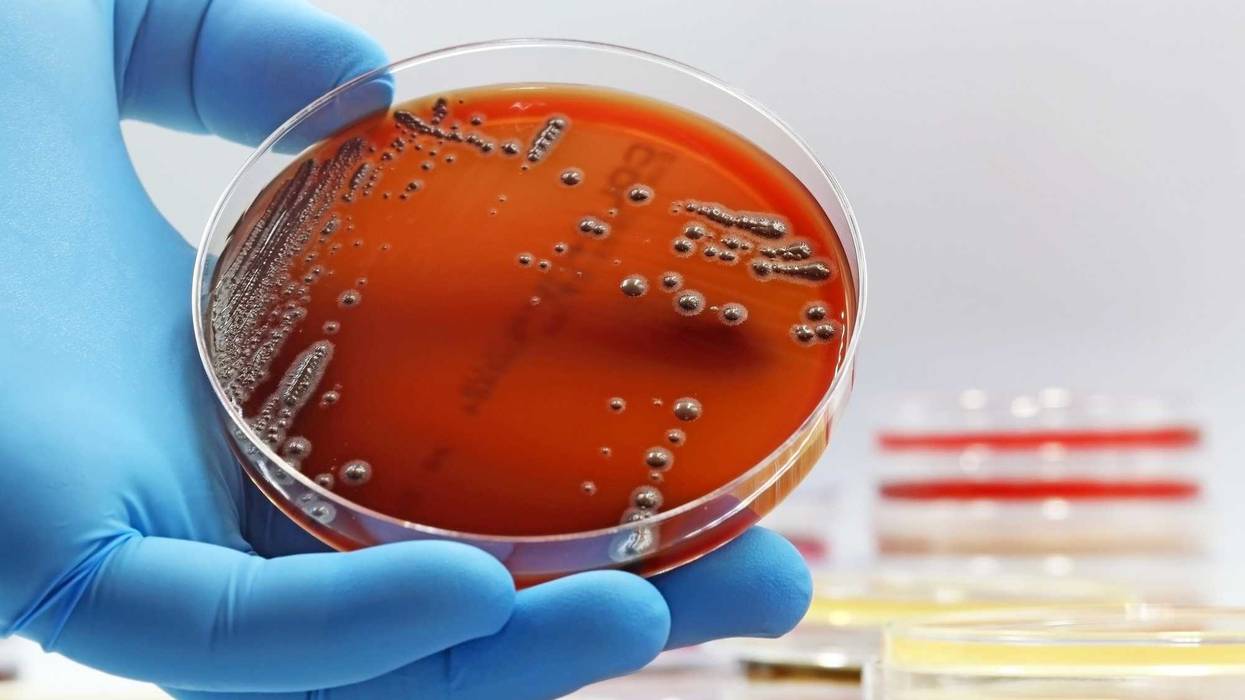
gloved hand with Petri dish

(WBBM NEWSRADIO) – At least 20 people contracted Salmonella after eating prepared food at an Avondale restaurant, Chicago city health officials said Friday.
Ten of the infected individuals were hospitalized after eating food from Carniceria Guanajuato, 3140 N. California, according to the Chicago Department of Public Health.
The restaurant voluntarily closed on Sept. 8 and is cooperating with the department to help find a source of the infections, officials said.
Anyone who has purchased food from establishment since Aug. 29 is urged to dispose of it.
People with Salmonella may develop diarrhea, fever, and abdominal cramps between 6 hours and 6 days after eating contaminated food.
Listen to our new podcast Looped In: Chicago
Listen to WBBM Newsradio now on Audacy!
Sign up and follow WBBM Newsradio
Facebook | Twitter | Instagram